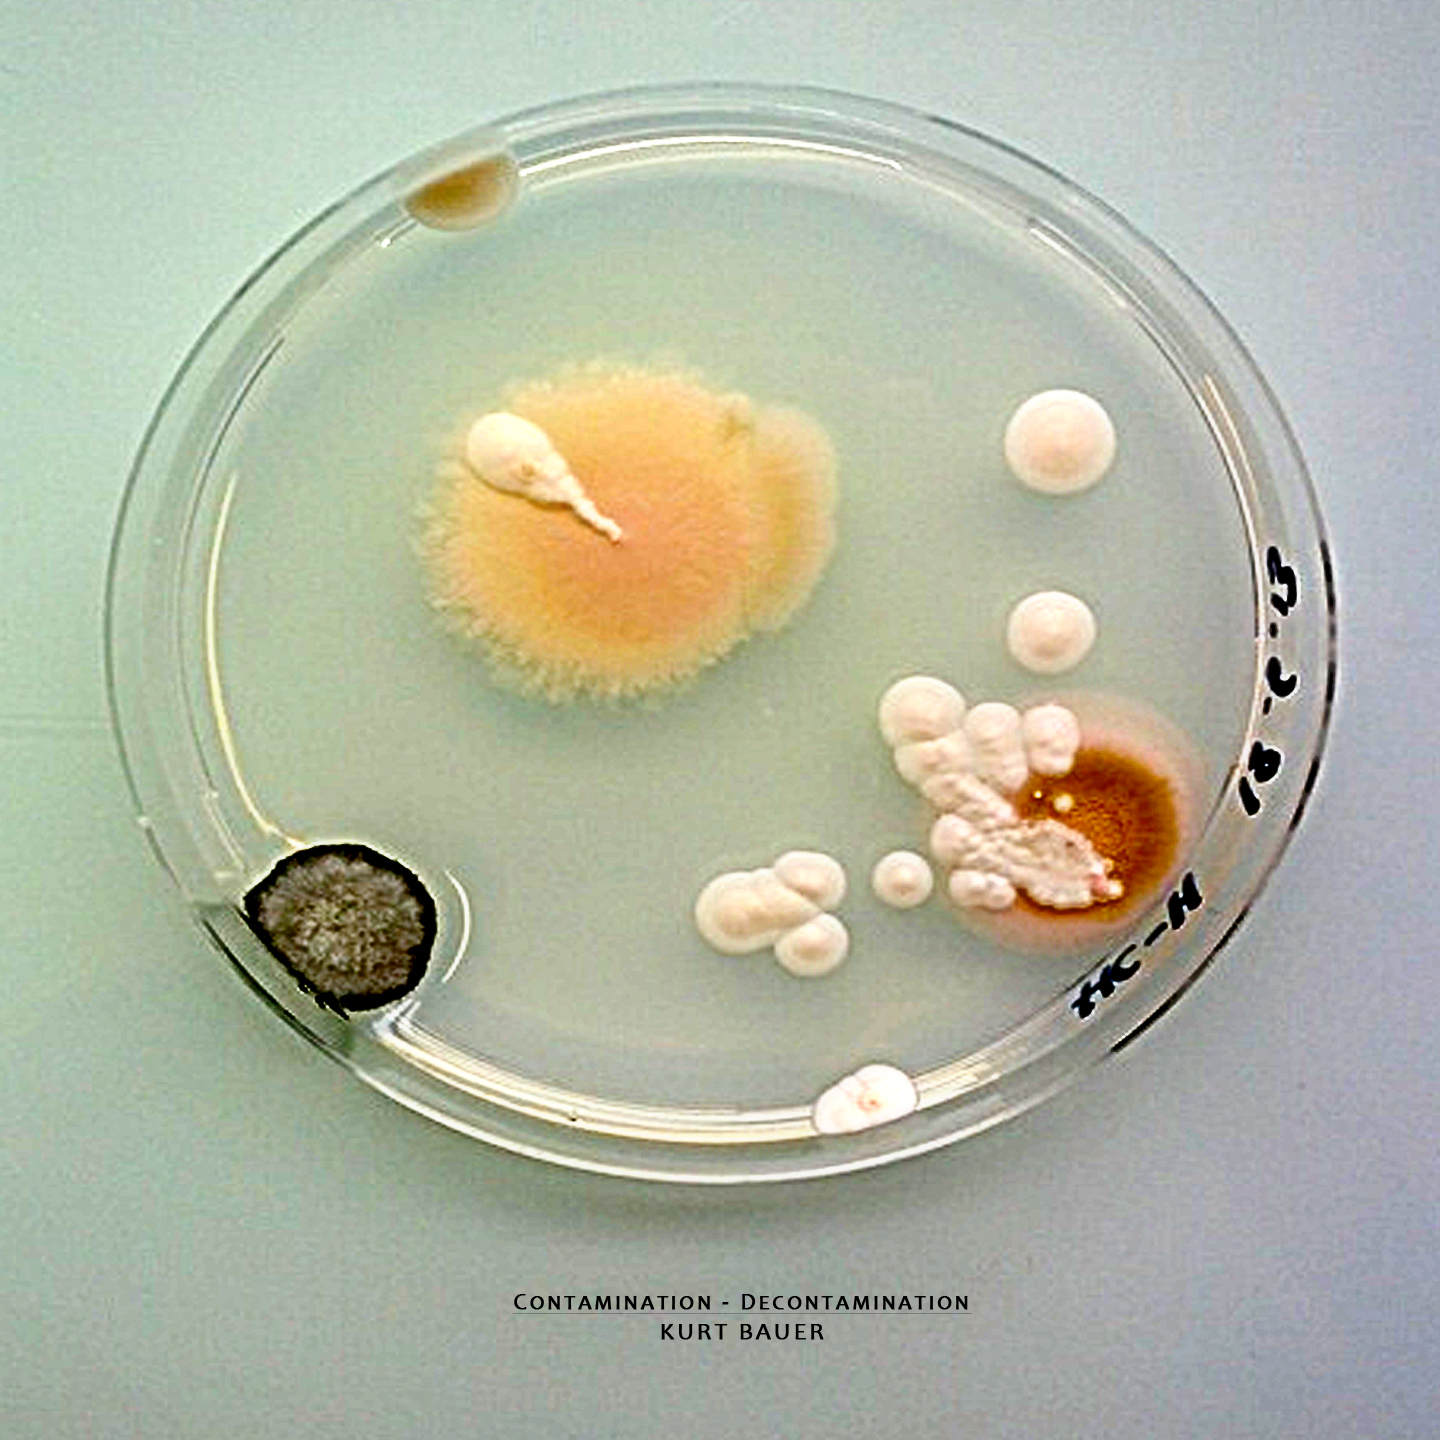

Contamination - Decontamination by Kurt Bauer
Tracklist
Credits
released September 9, 2014
Kurt Bauer - Prepared Heat Sink, Acoustic Laptop, Coffee Maker
Gordon Pryor - Food Prep/Cooking - Tracks 2,3,4
Kurt Bauer - Prepared Heat Sink, Acoustic Laptop, Coffee Maker
Gordon Pryor - Food Prep/Cooking - Tracks 2,3,4